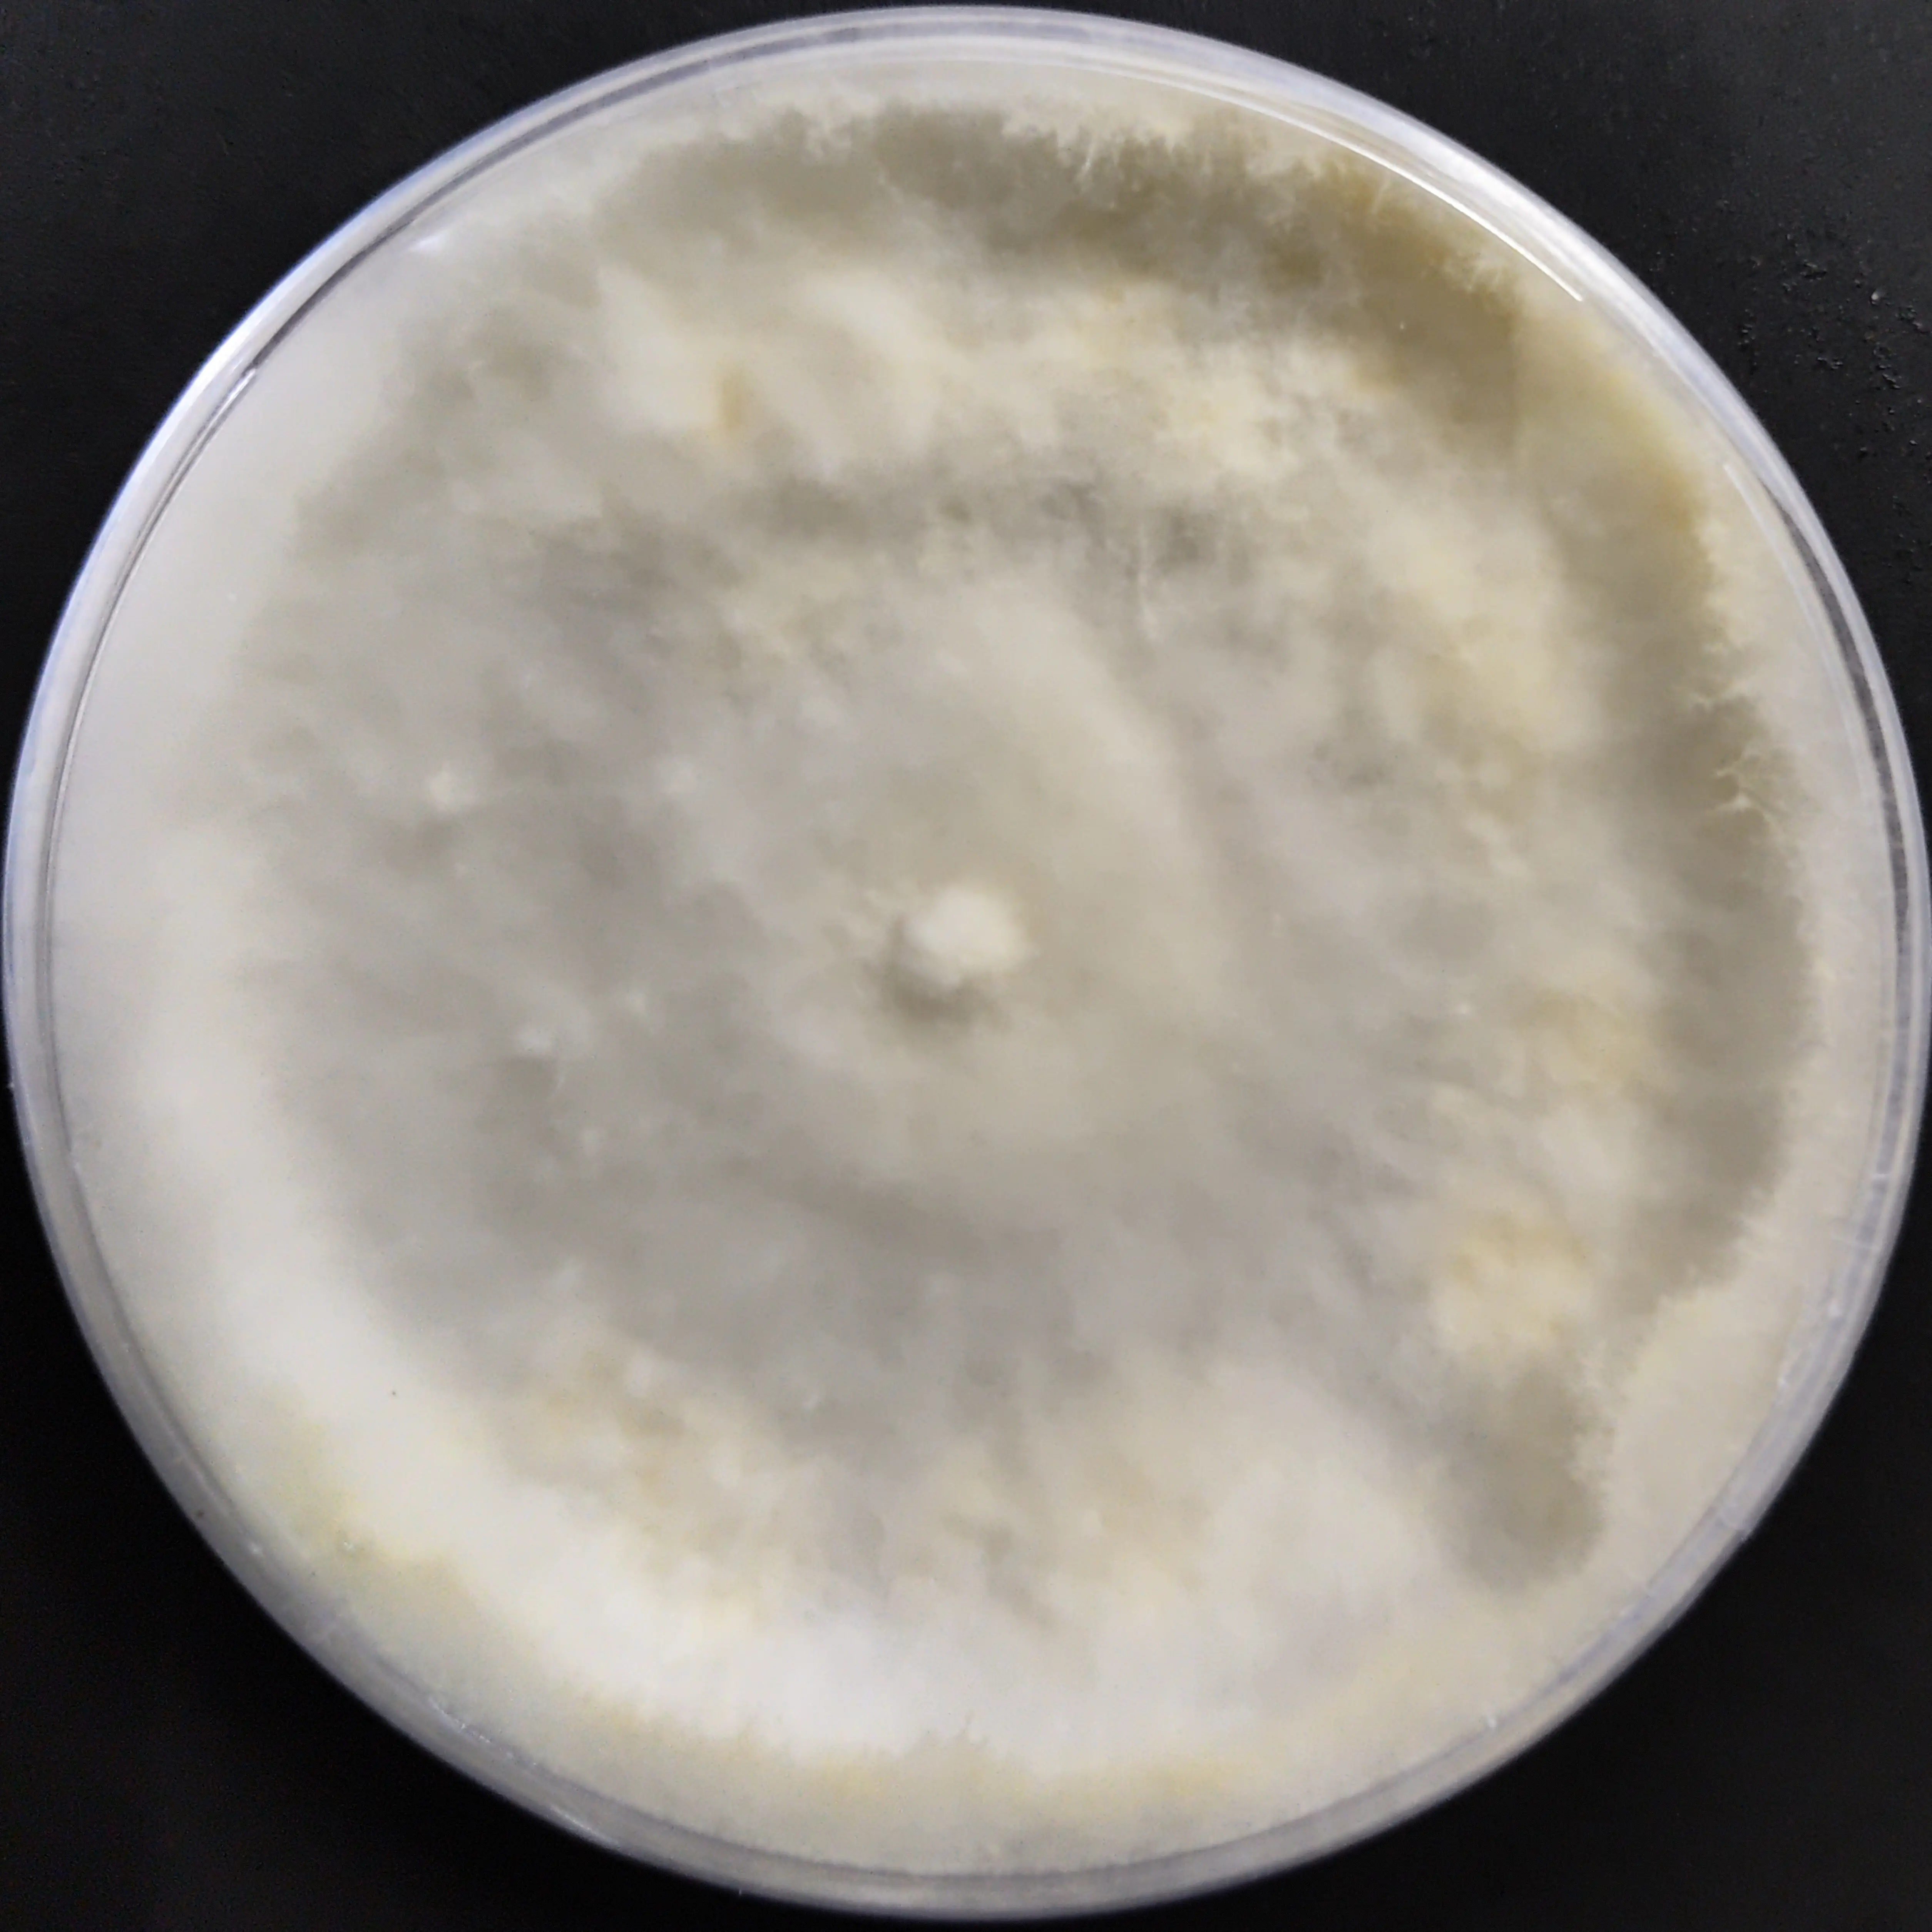
Lentinus sajor-caju Pure Culture
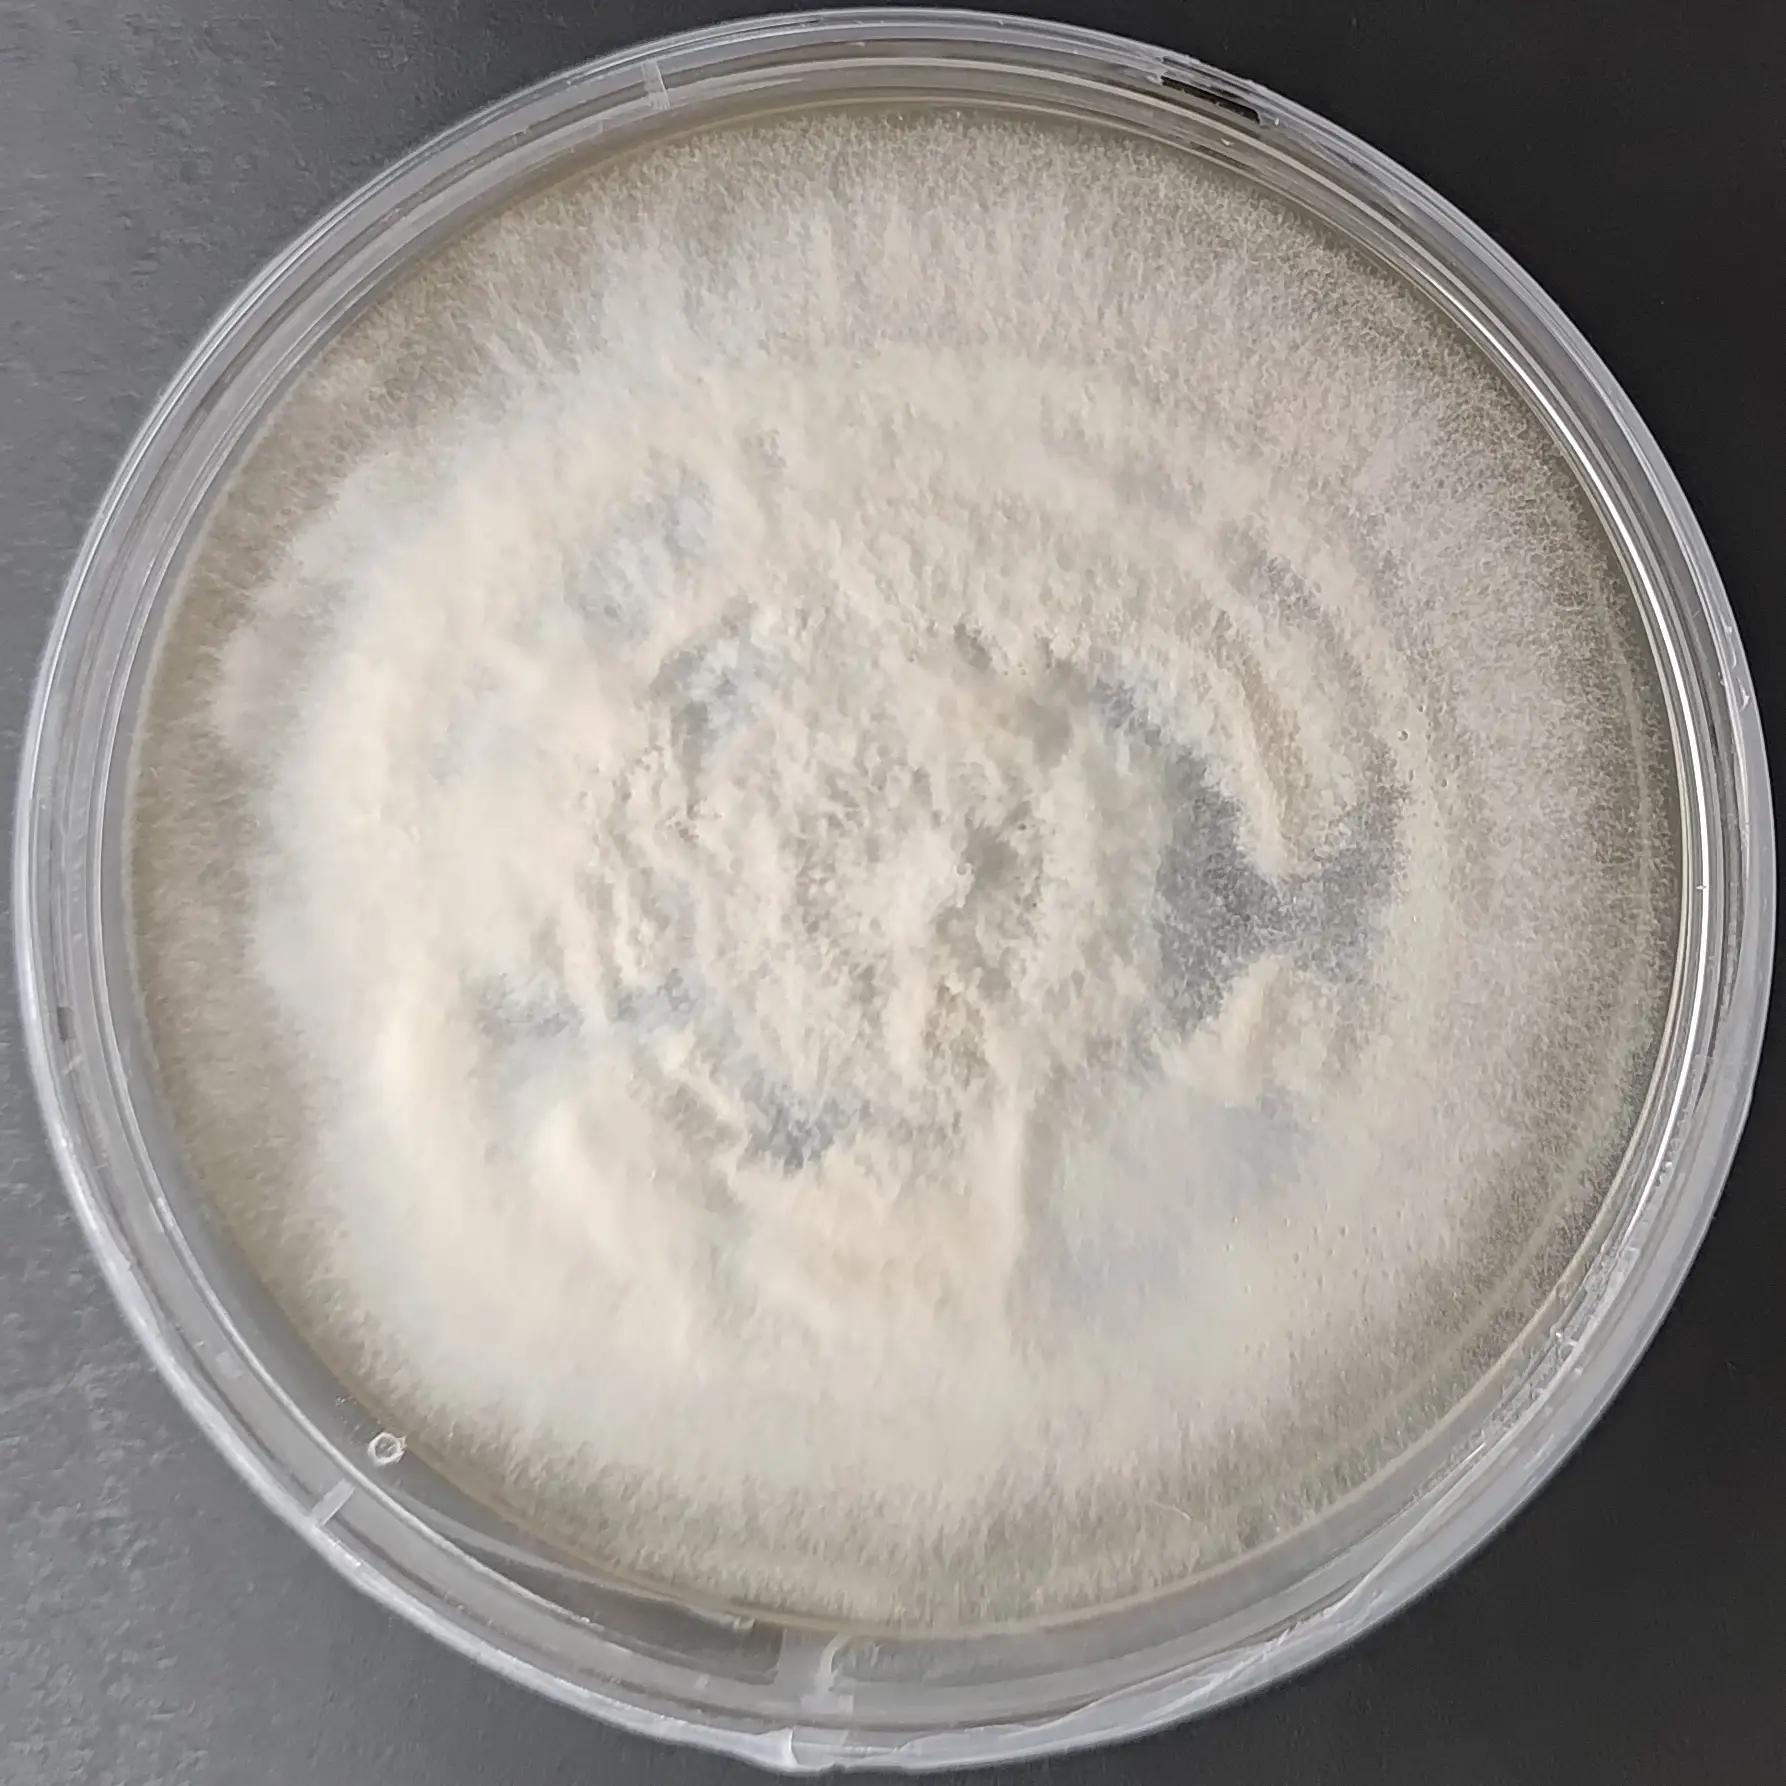
F90 Lignosus rhinocerus.webp

Lentinus sajor-caju Pure Culture
Lignosus rhinocerus Pure Culture (Tiger milk mushroom)
MUHSROOM CULTURE BANK PURE CULTURE - MEDICINAL MUSHROOMS PURE CULTURE - SPECIALTY MUSHROOMS All Products
Lion’s Mane Mushroom culture Plate (Hericium erinaceus)
Liquid Culture – Rare Ecological Mushrooms
Rare ecological mushrooms represent a unique group of fungi valued for their distinct life cycles, ecological roles, and research significance
Select options
This product has multiple variants. The options may be chosen on the product page
Liquid Culture – Functional Lignicolous Mushrooms
Functional lignicolous mushrooms are wood-growing fungi recognized for their culinary value, medicinal potential, and ecological function. These species naturally colonize
Select options
This product has multiple variants. The options may be chosen on the product page
Liquid Culture Agaricus Mushrooms
The genus Agaricus represents one of the most important and widely cultivated groups of mushrooms globally, valued for its culinary
Select options
This product has multiple variants. The options may be chosen on the product page
Liquid Culture Cordyceps militaris
Liquid Culture Medicinal Mushrooms
Liquid Culture – Medicinal Mushrooms Agripie’s Liquid Culture for Medicinal Mushrooms is a high-purity, laboratory-propagated fungal mycelium suspended in a
Select options
This product has multiple variants. The options may be chosen on the product page
Liquid Culture Morel Mushrooms
Morel mushrooms (Morchella spp.) are among the world’s most prized and scientifically intriguing fungi, valued for their exceptional culinary status,
Select options
This product has multiple variants. The options may be chosen on the product page
Liquid Culture Oyster Mushrooms
The Liquid Culture Syringe – Oyster Mushrooms is a laboratory-prepared, contamination-free inoculum containing fast-growing oyster mushroom mycelium suspended in a
Select options
This product has multiple variants. The options may be chosen on the product page
Liquid Culture Premium Culinary Mushrooms
Premium culinary mushrooms are valued worldwide for their exceptional flavor, aroma, texture, and gastronomic versatility. Agripie’s Liquid Culture – Premium
Select options
This product has multiple variants. The options may be chosen on the product page
Liquid Culture Tropical Culinary Mushroom
Tropical Culinary mushrooms represent a curated group of warm-climate, fast-growing, and commercially proven mushroom species that thrive under tropical and subtropical
Select options
This product has multiple variants. The options may be chosen on the product page